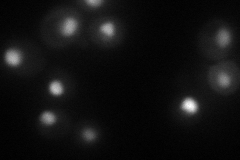

View description
DNA damage-dependent checkpoint protein, required for cell-cycle arrest in G1/S, intra-S, and G2/M; transmits checkpoint signal by activating Rad53p and Chk1p; hyperphosphorylated by Mec1p and Tel1p; potential Cdc28p substrate
Localization:
Intensity:
Fold change:
Significance:
-
C’ GFP library in SD

nucleus23.86 -
N' NOP1pr-GFP in SD

nucleolus87.0117 -
N' TEF2pr-mCherry in SD
nucleus68.665 -
N' NATIVEpr-GFP in SD

nucleus25.6885 -
N' TEF2pr-VC and Cyto-VN in SD

#N/A0 -
C’ GFP library in SD+DTT

nucleus16.610.69Yes -
C’ GFP library in SD+H2O2

nucleus25.421.06No -
C’ GFP library in Starvation Media

nucleus18.450.77Yes -
C’ GFP library on the background of Pup2-DaMP

nucleus -
C’ GFP library on the background of CCT mutant

nucleus23.49410.984283No
